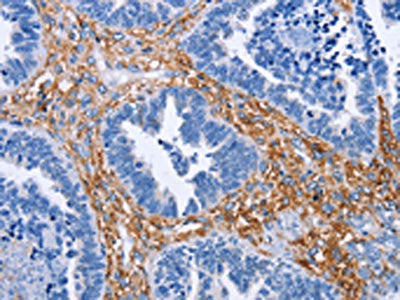
PLK1 Antibody

1
/
of
1
Cusabio
SKU:CSB-PA107067
PLK1 Antibody
PLK1 Antibody
Regular price
$299.00 USD
Regular price
Sale price
$299.00 USD
Unit price
/
per
Shipping calculated at checkout.
Couldn't load pickup availability
Aliases: Cell cycle regulated protein kinase; PLK 1; PLK; PLK-1; plk1; PLK1_HUMAN; Polo like kinase 1; Polo-like kinase 1; Serine/threonine protein kinase 13; Serine/threonine protein kinase PLK1; Serine/threonine-protein kinase 13; Serine/threonine-protein kinase PLK1; STPK 13; STPK13
Antibody Type: Polyclonal Antibody
Antigen Species: Human
Uniprot ID: P53350
Antigen: Fusion protein of Human PLK1
Host Species: Rabbit
Species Reactivity: Human, Mouse, Rat
Tested Applications: ELISA, IHC; ELISA:1:1000-1:2000, IHC:1:15-1:50
Clonality: Polyclonal
Isotype: IgG
Purification Method: Antigen affinity purification
Conjugate: Non-conjugated
Buffer: PBS, 0.05% sodium azide, 40% glycerol, pH 7.4.
Form: Liquid
Stroage: Upon receipt, store at -20°C or -80°C. Avoid repeated freeze.
Target Name: PLK1
Research Area: Cell Biology
Antibody Type: Polyclonal Antibody
Antigen Species: Human
Uniprot ID: P53350
Antigen: Fusion protein of Human PLK1
Host Species: Rabbit
Species Reactivity: Human, Mouse, Rat
Tested Applications: ELISA, IHC; ELISA:1:1000-1:2000, IHC:1:15-1:50
Clonality: Polyclonal
Isotype: IgG
Purification Method: Antigen affinity purification
Conjugate: Non-conjugated
Buffer: PBS, 0.05% sodium azide, 40% glycerol, pH 7.4.
Form: Liquid
Stroage: Upon receipt, store at -20°C or -80°C. Avoid repeated freeze.
Target Name: PLK1
Research Area: Cell Biology
Share